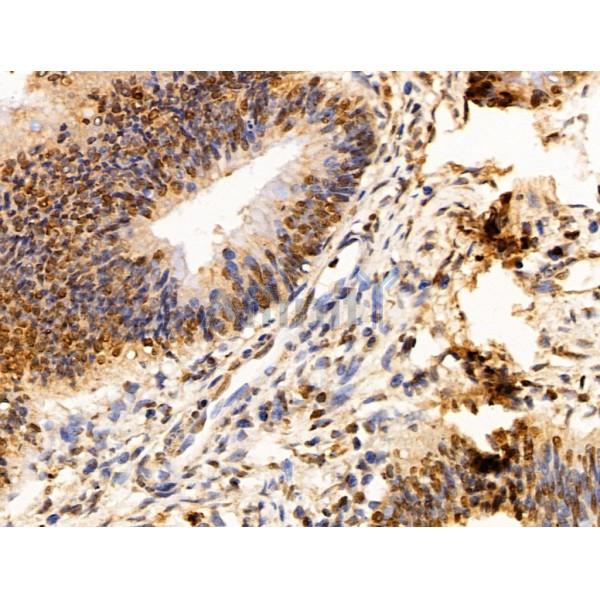
SET Antibody - DF13529 at 1/100 staining Human colorectal cancer by IHC-P.

SET Antibody - #DF13529
| Product: | SET Antibody |
| Catalog: | DF13529 |
| Description: | Rabbit polyclonal antibody to SET |
| Application: | WB IHC IF/ICC |
| Cited expt.: | WB, IF/ICC |
| Reactivity: | Human, Rat |
| Mol.Wt.: | 33kDa; 33kD(Calculated). |
| Uniprot: | Q01105 |
| RRID: | AB_2846548 |
Related Downloads
Protocols
Product Info
*The optimal dilutions should be determined by the end user. For optimal experimental results, antibody reuse is not recommended.
*Tips:
WB: For western blot detection of denatured protein samples. IHC: For immunohistochemical detection of paraffin sections (IHC-p) or frozen sections (IHC-f) of tissue samples. IF/ICC: For immunofluorescence detection of cell samples. ELISA(peptide): For ELISA detection of antigenic peptide.
Cite Format: Affinity Biosciences Cat# DF13529, RRID:AB_2846548.
Fold/Unfold
2PP2A; HLA DR associated protein II; HLA-DR-associated protein II; I 2PP2A; I-2PP2A; I2PP2A; IGAAD; Inhibitor of granzyme A activated DNase; Inhibitor of granzyme A-activated DNase; Inhibitor of GzmA-activated DNase; inhibitor-2 of protein phosphatase-2A; IPP2A2; PHAPII; Phosphatase 2A inhibitor I2PP2A; protein phosphatase type 2A inhibitor; Protein SET; Set; SET nuclear oncogene; SET translocation; SET translocation (myeloid leukemia-associated); SET_HUMAN; TAF I; TAF IBETA; TAF-I; TAFI; Template activating factor I; Template-activating factor I; Template-Activating Factor-I, chromatin remodelling factor;
Immunogens
A synthesized peptide derived from human SET, corresponding to a region within N-terminal amino acids.
Widely expressed. Low levels in quiescent cells during serum starvation, contact inhibition or differentiation. Highly expressed in Wilms' tumor.
- Q01105 SET_HUMAN:
- Protein BLAST With
- NCBI/
- ExPASy/
- Uniprot
MAPKRQSPLPPQKKKPRPPPALGPEETSASAGLPKKGEKEQQEAIEHIDEVQNEIDRLNEQASEEILKVEQKYNKLRQPFFQKRSELIAKIPNFWVTTFVNHPQVSALLGEEDEEALHYLTRVEVTEFEDIKSGYRIDFYFDENPYFENKVLSKEFHLNESGDPSSKSTEIKWKSGKDLTKRSSQTQNKASRKRQHEEPESFFTWFTDHSDAGADELGEVIKDDIWPNPLQYYLVPDMDDEEGEGEEDDDDDEEEEGLEDIDEEGDEDEGEEDEDDDEGEEGEEDEGEDD
Research Backgrounds
Multitasking protein, involved in apoptosis, transcription, nucleosome assembly and histone chaperoning. Isoform 2 anti-apoptotic activity is mediated by inhibition of the GZMA-activated DNase, NME1. In the course of cytotoxic T-lymphocyte (CTL)-induced apoptosis, GZMA cleaves SET, disrupting its binding to NME1 and releasing NME1 inhibition. Isoform 1 and isoform 2 are potent inhibitors of protein phosphatase 2A. Isoform 1 and isoform 2 inhibit EP300/CREBBP and PCAF-mediated acetylation of histones (HAT) and nucleosomes, most probably by masking the accessibility of lysines of histones to the acetylases. The predominant target for inhibition is histone H4. HAT inhibition leads to silencing of HAT-dependent transcription and prevents active demethylation of DNA. Both isoforms stimulate DNA replication of the adenovirus genome complexed with viral core proteins; however, isoform 2 specific activity is higher.
Isoform 2 is phosphorylated on Ser-15 and Ser-24.
Isoform 2 is acetylated on Lys-11.
Some glutamate residues are glycylated by TTLL8. This modification occurs exclusively on glutamate residues and results in a glycine chain on the gamma-carboxyl group (By similarity).
N-terminus of isoform 1 is methylated by METTL11A/NTM1. Mainly trimethylated (By similarity).
Cleaved after Lys-176 by GZMA. The cleavage inhibits its nucleosome assembly activity and disrupts the inhibition on NME1.
Cytoplasm>Cytosol. Endoplasmic reticulum. Nucleus>Nucleoplasm.
Note: In the cytoplasm, found both in the cytosol and associated with the endoplasmic reticulum. The SET complex is associated with the endoplasmic reticulum. Following CTL attack and cleavage by GZMA, moves rapidly to the nucleus, where it is found in the nucleoplasm, avoiding the nucleolus. Similar translocation to the nucleus is also observed for lymphocyte-activated killer cells after the addition of calcium.
Widely expressed. Low levels in quiescent cells during serum starvation, contact inhibition or differentiation. Highly expressed in Wilms' tumor.
A long alpha helix in the N-terminus mediates dimerization, while the earmuff domain is responsible for core histone and dsDNA binding. The C-terminal acidic domain mediates the inhibition of histone acetyltransferases and is required for the DNA replication stimulatory activity.
Belongs to the nucleosome assembly protein (NAP) family.
References
Application: WB Species: Rat Sample:
Application: IF/ICC Species: Rat Sample:
Restrictive clause
Affinity Biosciences tests all products strictly. Citations are provided as a resource for additional applications that have not been validated by Affinity Biosciences. Please choose the appropriate format for each application and consult Materials and Methods sections for additional details about the use of any product in these publications.
For Research Use Only.
Not for use in diagnostic or therapeutic procedures. Not for resale. Not for distribution without written consent. Affinity Biosciences will not be held responsible for patent infringement or other violations that may occur with the use of our products. Affinity Biosciences, Affinity Biosciences Logo and all other trademarks are the property of Affinity Biosciences LTD.